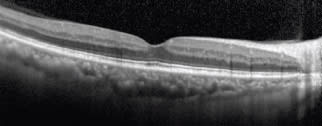

Journal Club
Recent Noteworthy Studies to Stimulate Discussion and Debate
■ Longer-wavelength OCT studied in AMD. As OCT (Figure 1) technologies continue to improve, we are gaining increasing knowledge of how age-related macular degeneration affects the structures of the eye. Using a longer-wavelength (1060 nm), three-dimensional optical coherence tomography device, scientists in the United Kingdom examined the eyes of patients in the early stages of dry AMD to compare retinal and choroidal thickness vs healthy controls. They report their findings in the December 2011 issue of the American Journal of Ophthalmology.

Figure 1. Improved OCT technology has been applied to compare retinal and choroidal thickness in the eyes of patients with early AMD. COURTESY OF PETER K. KAISER, MD
Sixteen patients and 16 control subjects were recruited and underwent OCT. Three-dimensional images were acquired at 8 µm resolution and 47,000 A-scans per second. Retinal thickness was measured from the ILM to the RPE, while choroidal thickness was measured from the RPE to the choroid-scleral interface. Seventeen images were taken per patient.
The study authors found that mean retinal thickness was significantly reduced in the patient group when compared to the control group at multiple locations within 2 mm of the fovea. The greatest difference was found at the fovea itself, where retinal thickness was 179 ±27 µm for the patient group and 202 ±18 µm for the control group. There was no difference in choroidal thickness detected between the two study groups.
Among other explanations, the study authors suggest that the reduction in retinal thickness was a result of photo receptor degeneration brought about by the presence of overlying drusen. They conclude that choroidal thickness is unchanged in the early disease process of AMD, but they also recommend larger studies to confirm their findings.
■ Permanent silicone oil tamponade. Silicone oil is al ready used as a tamponade for periods of weeks to months, and some particularly complicated and severe cases may require permanent tamponading with silicone oil. However, the long-term effects of such a tamponade are unknown. To provide some insight, retinal surgeons at the Royal Liverpool University Hospital in the United Kingdom have had a study published online by Graefe's Archive of Clinical and Experimental Ophthalmology.
The authors retrospectively studied 50 patients who had been tamponaded with silicone oil for at least 12 months. The pathologies of the patients studied were several, but the most common were retinal redetachment, proliferative diabetic retinopathy, ocular trauma and persistent hypotony. All patients were tamponaded with Bausch + Lomb's Oxane 5700 silicone oil.
The mean duration of silicone oil in the studied eyes was 54.5 ±58.6 months, and the average number of surgeries before tamponade was 2.2 ±1.5. There was anatomic success achieved in 37 of 50 cases (74%). At follow-up appointments at three months and one year and at the last recorded follow-up, logMAR visual acuity and intraocular pressure remained consistent. The most common adverse events were optic neuropathy, iris rubeosis and corneal decompensation.
Because these complications occurred at significant rates, and because the actual number of patients who achieved stereopsis and who benefitted functionally was quite low (14%), the authors emphasize that long-term or permanent silicone oil tamponade should only be used as a last resort in severe cases.
Nevertheless, the ambulatory vision rate of 40% bears out continued use of silicone oil in this fashion in those cases.
■ Blood thinners and diabetic vitrectomy. With diabetes and anticoagulant therapy both being common in elderly patients, it is not surprising that many patients undergoing diabetic vitrectomy are taking blood thinners. Thus, the risks of perioperative hemorrhage in these patients is well known. However, the risks of a patient discontinuing anticoagulant therapy are also important. To provide more information to weigh these risks, the November 2011 issue of Retina has an article on this topic.
The study authors, from the Kresge Eye Institute at Wayne State University in Detroit, conducted a retrospective, comparative cohort study of the patients at their center who underwent diabetic vitrectomy over a 30-month period, from November 2006 to June 2009. Ninety-seven eyes were included in their analysis, 27 of which were in patients who continued anticoagulation therapy during the perioperative period and who formed the noncontrol group.
There were also no perioperative complications that arose as a result of the anticoagulant drugs being used. Further, there was no statistically significant difference in the incidence of postoperative vitreous hemorrhage between the group taking anticoagulants and controls. In addition, both groups experienced significant gains in acuity, although when postoperative visual acuity was compared between the groups, the patients not on anticoagulant therapy had better visual acuity, on average (20/100 vs 20/230). The authors believe this difference was likely a result of the greater vascular damage generally seen in the eyes of patients on blood thinners.
Based on these findings, the study authors recommend that patients undergoing diabetic vitrectomy be maintained on anticoagulant medications if taken for systemic diseases.
■ Endophthalmitis prevention. As controversy continues to rage over the proper use of endophthalmitis prophylaxis with intravitreal injection procedures, the November 2011 issue of Retina features a study from the Medical College of Wisconsin, which concludes that postinjection antibiotics may not make a difference in preventing this potentially devastating complication (Figure 2).

Figure 2. Postinjection antibiotics may not make a difference in preventing endophthalmitis. COURTESY OF PETER K. KAISER, MD
To assess the effectiveness of postinjection antibiotics, the study authors conducted a retrospective chart review for a 12-month period during which patients received postinjection topical antibiotics for several days and compared the data from that period with a subsequent 12-month period during which postinjection antibiotics were not used. The two periods saw 2,287 and 2,480 patients treated, respectively.
In both study cohorts, five cases of endophthalmitis were suspected (0.22% and 0.20%, respectively). Only one case was culture-proven (for Streptococcus viridans), and this case occurred in the latter cohort, which did not receive postinjection antibiotics, yielding a cultureproven endophthalmitis rate of 0.04%. This patient was treated by pars plana vitrectomy.
The difference between the groups was not statistically significant (P = .75). Therefore, the authors state that their findings confirm increasing suspicion that postinjection topical antibiotics have little or no effect, if only because bacterial endophthalmitis occurs as a result of the vitreous being directly infected, and topical bacteria rarely play a role. While further research is warranted, the increasing risk of antibiotics resistance may warrant changing protocols.
■ Lucentis in three-line losers. The MARINA and ANCHOR trials proved the efficacy of ranibizumab for wet AMD, but not all patients treated experienced vision gains or even maintenance of pre-existing visual acuity. Some patients experienced acute vision loss of three lines or more of ETDRS visual acuity in the first year of treatment. To determine longterm outcomes in these patients, a collaborative effort among several European ophthalmologists was undertaken, with the results of their study appearing in the December 2011 issue of the British Journal of Ophthalmology.
The authors performed two retrospective analyses using the MARINA and ANCHOR data. Because there were sham-treated patients in these trials, study cohorts were formed of patients who received ranibizumab and lost three or more lines of vision and of patients who were sham-treated and had similar vision loss. The visit at which the vision loss was detected was treated as the baseline for this study.
The results of the study indicated that patients treated with ranibizumab gained 11.9 ETDRS letters, on average, from the new baseline, compared to only 0.3 letters in the sham-treated group. The authors were careful to control their data for possible factors that might have explained the visual acuity recovery seen in the ranibizumab-treated patients, nor were there any demographic variables that appeared to play a role.
The lesson of this study is clear: Even in those patients who experience very significant vision loss during two years of treatment with ranibizumab, continued treatment with the same drug tended very strongly to recover lost vision. The authors recommend continued monthly treatment in such patients; however, given ongoing research on optimal dosing regimens for ranibizumab, they do not recommend a specific length of time for retreatment. RP
CLINICAL CASE REPORTS
MicroPulse™ Laser Therapy of Diabetic Macular Edema Success in Anti-VEGF Non-responder

Sam E. Mansour, MSc, MD, FRCS(C), FACS, is Medical Director of the Virginia Retina Center in Warrenton, Va., and Clinical Professor of Ophthalmology at the George Washington University School of Medicine in Washington, D.C. Contact him at sm@virginiaretina.com or (703) 443-0015.
History and examination
A 69-year-old woman with Type 2 diabetes mellitus was referred to our clinic after being treated unsuccessfully elsewhere. Her records indicated a three-year history of clinically significant diabetic macular edema (CSDME). She already had received multiple injections of intravitreal bevacizumab (Avastin, Genentech) and triamcinolone in both eyes, with little or very transient effect. Her left eye also had received focal laser treatment.
Upon examination, the laser-treated left eye had minimal edema but was the worse-seeing eye (20/80−2) due to laserinduced scotomas. The patient was very unhappy about her decreased vision and had refused subsequent laser treatment in the other eye because of her dissatisfaction. In the dominant right eye, optical coherence tomography (OCT) and fluorescein angiography (FA) revealed clinically significant macular edema (Figs 1, 2). Central retinal thickness was 326 µm and visual acuity (VA) was 20/50−1.

Figure 1. Pre-MicroPulse Laser Treatment: SD-OCT (Spectralis) CSDME Right Eye. Central retinal thickness: 326 μm.

Figure 2. Pre-MicroPulse Laser Treatment: FA CSDME Right Eye. VA: 20/50−1
Tissue-Sparing Treatment
This patient had to be convinced to undergo a different type of laser therapy. In July, I treated the right eye with the IRIDEX IQ 577™ laser.
First, I used the laser in continuous-wave (CW) mode to very lightly cauterize a few microaneurysms. To determine the power for the MicroPulse™ laser therapy, I performed a CW test burn in a non-edematous area of the retina, outside the vascular arcade with a 100 µm spot. I typically start at 100 mW and slowly increase the power by 50-mW increments until I get a barely visible burn. I double that power setting when I switch to MicroPulse mode for the subvisible (no endpoint), confluent grid treatment. Typically, MicroPulse power ranges from 200-800 mW. In this case, I used 500 mW at a 5% duty cycle and 200-ms duration (Table 1).
| TABLE 1:TREATMENT PARAMETERS | |
|---|---|
| IRIDEX IQ 577 for Diabetic Macular Edema | |
| Wavelength: | 577 nm |
| Test Burn in CW Mode | |
| Performed in non-edematous area of the retina, outside the vascular arcade. | |
| Spot size on slit lamp adapter: | 100 µm |
| Contact lens: | Mainster focal grid (laser magnification: 1.05x) |
| Power: | Start at 100 mW and increase power in 50 mW increments (moving to adjacent locations) until a barely visible burn is achieved. (250 mW in this case) |
| Exposure duration: | 100 ms |
| Subthreshold Treatment in MicroPulse Mode | |
| Spot size on slit lamp adapter: | 100 µm |
| Contact lens: | Mainster focal grid: (1.05x) |
| Power: | 2x power needed for test burn (500 mW in this case) |
| Exposure duration: | 200 ms (delivering a train of 100 micropulses per application) |
| Duty cycle: | 5% |
| Treatment pattern: | High density (confluent) grid over macular thickening |
| Endpoint: | Not visible – rely on objective post-treatment outcome measures (VA, OCT, FA) |
Immediate Result
The patient was seen for follow-up 6 weeks after treatment. After just the single treatment, there was a significant reduction in the retinal thickness, from 326 µm to 272 µm. As expected, there is no scarring or other visible sign of the laser spots (Figs 3, 4). Although the edema was not completely resolved, the VA improved by 2 lines, from 20/50−1 to 20/25−2. The patient was pleased with the visual improvement. At a second follow-up 6 weeks later, the edema continued to resolve so we have not yet repeated the laser or given any additional Avastin injections.
Figure 3. 6 Weeks Post-MicroPulse Treatment: Central retinal thickness: 272 μm

Figure 4. 6 Weeks Post-MicroPulse Treatment: VA: 20/25−1
Discussion and treatment pearls
In my experience with MicroPulse, the visual improvement is often out of proportion with respect to reduction in retinal thickness, as was the case with this patient. Certainly, there are different therapeutic mechanisms involved compared to conventional laser photocoagulation. Rather than causing cellular destruction, MicroPulse therapy uses laser light to photostimulate the retinal pigment epithelium (RPE) cells to balance the expression of biochemical factors that result in overall amelioration of the diabetes-induced vascular damage.
In addition to its MicroPulse capability, the IRIDEX IQ 577 laser was appealing to me because I can use it in CW mode to perform any other conventional procedure, from microaneurysm ablation to laser retinopexy. The yellow 577-nm wavelength is very safe for treating the macula because it is absorbed by the RPE, but not by the xanthophyll pigment in the fovea. If you have to pick one laser wavelength, I feel that 577-nm yellow light provides the greatest versatility and the best safety profile.
I do think it is important to spend some time educating patients—especially when they have had a previous laser experience—about what to expect from MicroPulse laser therapy. I tell patients they may need two to three treatments over several months, but that the end result will be a more significant and longer lasting improvement in vision with fewer side effects than any other treatment option currently available. In this case, no additional laser treatment was necessary at 3 months follow-up.
Role of MicroPulse™ in my practice
There have been several recent innovations in laser therapy. PASCAL, for example, is designed to quickly deliver a pattern of sequential laser spots. While useful, especially for panretinal photocoagulation, the treatment endpoint is still a burn. Conversely, MicroPulse technology modifies the CW laser energy in a train of on/off pulses that allows for thermal relaxation of the tissue during the “off” portion to avoid creating a thermo-destructive burn.
I admit that I was initially very skeptical of MicroPulse, considering it almost a “homeopathic” laser because of the lack of a visible endpoint. But with increasing evidence of its efficacy in the literature, I think we are all realizing that defining a therapeutic endpoint by the proportion of charred retina is actually quite primitive. We can now rely on objective VA, OCT, and FA to assess the efficacy of laser treatment, and the results have been excellent with no laser burns and collateral effects.
In my practice: MicroPulse has now completely replaced conventional laser for macular edema resulting from diabetes or retinal vein occlusion, and what remains to be explored is the optimal regimen of bevacizumab and triamcinolone that can be applied in combination with MicroPulse to maximize the prompt effect of intravitreal pharmacotherapy with the duration of laser treatment.
Treatment techniques and opinions presented in this case report are those of the author. IRIDEX assumes no responsibility for patient treatment, outcome, or for physicians' negligence.
IRIDEX, IRIDEX logo are registered trademarks, and MicroPulse is a trademark of IRIDEX Corporation.








